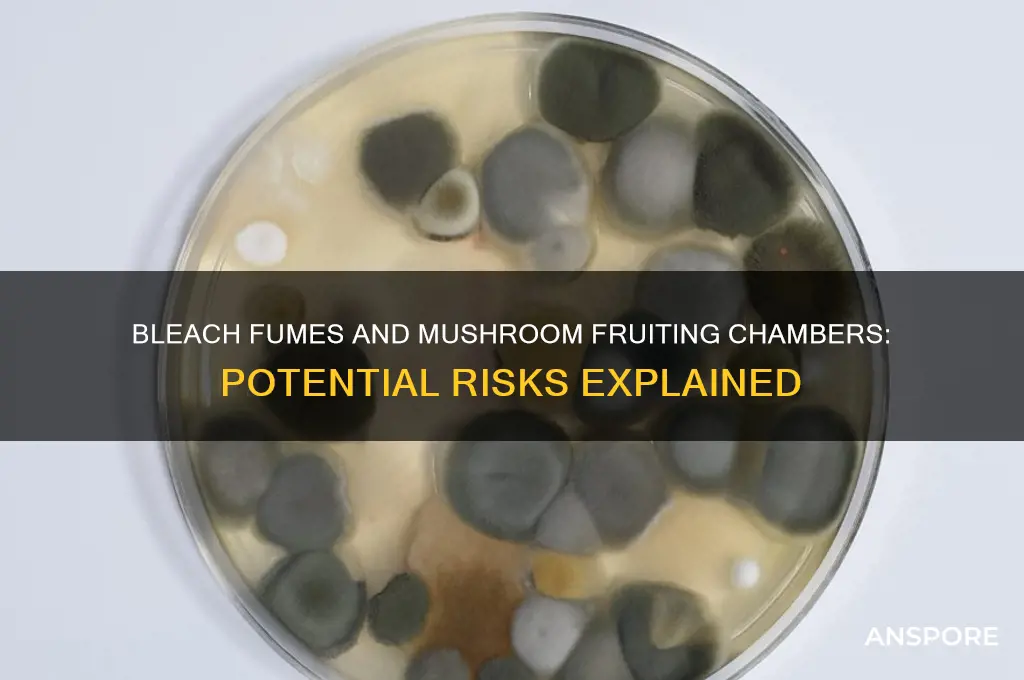
will bleach fumes hurt my fruiting chamber for growing mushrooms

When considering the use of bleach fumes in proximity to a fruiting chamber for growing mushrooms, it is essential to understand the potential risks involved. Bleach, a common household disinfectant, releases chlorine gas when mixed with other chemicals or even when used in high concentrations, which can be harmful to both humans and sensitive environments. Mushrooms, being particularly delicate during the fruiting stage, may suffer from exposure to these fumes, as they require specific humidity, temperature, and air quality conditions to thrive. Prolonged or direct exposure to bleach fumes can disrupt the mycelium’s growth, inhibit fruiting, or even kill the mushroom culture. Therefore, it is advisable to avoid using bleach near the fruiting chamber and opt for alternative, mushroom-safe cleaning agents or practices to maintain a sterile environment without compromising the health of your mushroom crop.
| Characteristics | Values |
|---|---|
| Bleach Fumes Impact on Fruiting Chamber | Potentially harmful due to chlorine gas release |
| Primary Concern | Chlorine gas can inhibit mushroom growth and damage mycelium |
| Safe Bleach Usage | Diluted bleach (1:10 ratio) for cleaning, followed by thorough rinsing and drying |
| Alternative Disinfectants | Hydrogen peroxide (3%), vinegar, or alcohol-based solutions recommended |
| Ventilation Importance | Proper ventilation crucial to dissipate fumes and prevent buildup |
| Exposure Duration | Short-term exposure (minutes) less harmful than prolonged exposure (hours) |
| Mushroom Species Sensitivity | Some species more sensitive to bleach fumes than others (e.g., oyster mushrooms more tolerant) |
| Preventive Measures | Avoid using bleach during active fruiting, seal containers properly, and monitor humidity levels |
| Recovery Possibility | Mycelium may recover if exposure is minimal and conditions are optimized afterward |
| Expert Recommendation | Minimize bleach use; prioritize alternative disinfectants and proper sanitation practices |
Explore related products
$37.99
What You'll Learn
- Ventilation Needs: Adequate airflow prevents bleach fumes from accumulating in the fruiting chamber
- Residue Risks: Bleach residue can harm mycelium if not rinsed thoroughly before use
- Fume Exposure Time: Limit bleach use to short periods to minimize fume impact
- Material Compatibility: Ensure chamber materials (plastic, wood) are resistant to bleach damage
- Alternative Sanitizers: Consider hydrogen peroxide or vinegar as safer mushroom-friendly disinfectants

Ventilation Needs: Adequate airflow prevents bleach fumes from accumulating in the fruiting chamber
When using bleach for sterilization or cleaning in a mushroom fruiting chamber, ensuring proper ventilation is critical to prevent the accumulation of harmful fumes. Bleach releases chlorine gas when mixed with other substances like ammonia or even organic matter, which can be toxic to both mushrooms and humans. Adequate airflow is the first line of defense against these fumes, as it dilutes and disperses them before they can reach harmful concentrations. Without proper ventilation, bleach fumes can linger, potentially damaging mycelium, inhibiting fruiting, and creating an unsafe environment for cultivation.
To address ventilation needs, start by ensuring your fruiting chamber has a continuous exchange of fresh air. This can be achieved through passive methods, such as leaving small gaps in the chamber or using air vents, or active methods, like installing exhaust fans or air pumps. The goal is to create a steady flow of air that moves through the chamber, carrying fumes away from the growing environment. For smaller setups, a simple desktop fan directed outward can suffice, while larger operations may require more robust ventilation systems to maintain airflow.
In addition to mechanical ventilation, consider the placement of your fruiting chamber. Position it in a well-ventilated area, away from enclosed spaces where fumes could stagnate. If using bleach for cleaning, perform the task outside the chamber or in a separate, well-ventilated room, and allow the cleaned items to fully air out before reintroducing them. This minimizes the risk of residual fumes entering the fruiting chamber and affecting your crop.
Monitoring airflow is equally important. Use tools like smoke tests or airflow meters to ensure air is moving effectively through the chamber. Aim for a turnover rate that replaces the entire volume of air in the chamber at least once every 5–10 minutes. This frequency helps prevent fume buildup while maintaining the humidity and temperature levels necessary for mushroom fruiting. Regularly inspect ventilation systems for blockages or malfunctions to ensure consistent performance.
Finally, combine ventilation with other safety practices to maximize protection. Always wear gloves and a mask when handling bleach, and avoid mixing it with other cleaning agents. If bleach fumes are detected in the fruiting chamber, immediately increase airflow and remove any contaminated materials. By prioritizing ventilation, you not only safeguard your mushroom crop but also create a safer workspace for yourself. Proper airflow is non-negotiable when using bleach near a fruiting chamber, as it directly prevents the harmful effects of fume accumulation.
Mastering Monotub Mushroom Cultivation: A Step-by-Step Growing Guide
You may want to see also

Residue Risks: Bleach residue can harm mycelium if not rinsed thoroughly before use
When using bleach in your fruiting chamber or any part of your mushroom cultivation setup, the primary concern isn't just the fumes but the residue risks that can persist if not properly managed. Bleach is a powerful disinfectant, but its residual chemicals, such as chlorine, can be harmful to mycelium if left behind. Mycelium is sensitive to harsh chemicals, and even trace amounts of bleach residue can inhibit growth, weaken the mycelium, or even kill it entirely. This is why thorough rinsing is critical after using bleach as a sterilizing agent.
The risk of bleach residue is particularly high when cleaning surfaces that will come into direct contact with mycelium or substrates, such as fruiting chamber walls, trays, or tools. If bleach is not completely rinsed away, it can leach into the growing environment, disrupting the delicate balance required for mushroom cultivation. Chlorine, a common component of bleach, can oxidize organic matter and damage the cellular structure of mycelium, leading to stunted growth or contamination. To avoid this, always rinse surfaces multiple times with clean, sterile water after using bleach, ensuring no chemical traces remain.
Another consideration is the material of your fruiting chamber. Porous surfaces, like wood or unsealed concrete, can absorb bleach and release it slowly over time, posing a long-term risk to mycelium. Non-porous materials like glass, stainless steel, or sealed plastic are safer options, as they are less likely to retain bleach residue. If you must use porous materials, consider applying a food-safe sealant to minimize absorption and ensure thorough rinsing after cleaning.
For tools and equipment, such as scalpels or misting bottles, soak them in bleach solution only as long as necessary, then rinse them meticulously under running water. Follow this with a final rinse in sterile water to ensure no bleach remains. Even small amounts of residue on tools can transfer to your substrate or mycelium, causing unintended damage. Air-drying rinsed items in a clean environment can also help ensure no contaminants are introduced.
Lastly, while bleach fumes themselves are less likely to harm mycelium if the area is well-ventilated, the focus should always be on eliminating residue. If you're concerned about fumes, ensure your workspace is well-ventilated during cleaning, and allow ample time for the area to air out before reintroducing mycelium. However, the greater danger lies in the residual chemicals, which can persist long after the fumes have dissipated. Always prioritize thorough rinsing to protect your mycelium and ensure a successful harvest.
Best Grow Lights for Mushroom Cultivation: A Comprehensive Guide
You may want to see also

Fume Exposure Time: Limit bleach use to short periods to minimize fume impact
When using bleach in or around your fruiting chamber for growing mushrooms, it’s crucial to limit fume exposure time to minimize potential harm. Bleach fumes contain chlorine gas, which can be harmful to both the mycelium and the fruiting bodies of mushrooms. Prolonged exposure to these fumes can disrupt the delicate environment required for mushroom growth, leading to stunted development or even the death of the mycelium. To mitigate this risk, always restrict bleach use to short, controlled periods. For example, if you’re sterilizing surfaces or tools, apply bleach quickly and ventilate the area immediately afterward to disperse fumes.
The key to minimizing fume impact is to plan your bleach use strategically. Avoid leaving bleach solutions exposed for extended periods inside or near the fruiting chamber. Instead, apply bleach in a well-ventilated area away from the chamber, and ensure the treated items are thoroughly rinsed and dried before reintroducing them to the growing environment. If you must use bleach inside the fruiting chamber, limit the application to a few minutes and remove the bleach solution promptly. This reduces the time fumes linger and lowers the risk of damaging your mushroom crop.
Ventilation plays a critical role in reducing fume exposure time. Always work in a space with good airflow, and consider using fans or open windows to expedite the dispersal of bleach fumes. If your fruiting chamber is in a confined area, temporarily relocate it or ensure the space is thoroughly ventilated before and after bleach use. The goal is to minimize the concentration of fumes in the air, as even short exposure to high concentrations can be detrimental. Quick, efficient application followed by immediate ventilation is the best practice.
Another effective strategy is to use bleach alternatives when possible to further limit fume exposure. Hydrogen peroxide, vinegar, or specialized mushroom-friendly sanitizers are safer options that produce fewer harmful fumes. However, if bleach is necessary, dilute it to the minimum effective concentration and use it sparingly. For instance, a 1:10 bleach-to-water ratio is often sufficient for sterilization without generating excessive fumes. Always prioritize reducing the duration and intensity of fume exposure to protect your fruiting chamber.
Lastly, monitor your fruiting chamber closely after any bleach use to ensure there are no lingering effects. Signs of fume damage include slowed growth, discoloration, or abnormal fruiting. If you notice these symptoms, increase ventilation and consider relocating the chamber to a fresher environment. By strictly limiting bleach use to short periods and following these precautions, you can maintain a healthy fruiting chamber while minimizing the risks associated with fume exposure.
Mastering Mushroom Cultivation: A Guide to Using Agar for Optimal Growth
You may want to see also
Explore related products
$35.95 $38.43
$19.99 $25.99

Material Compatibility: Ensure chamber materials (plastic, wood) are resistant to bleach damage
When considering the use of bleach near your fruiting chamber for growing mushrooms, material compatibility is a critical factor to ensure the longevity and functionality of your setup. Bleach, a common household disinfectant, contains chlorine compounds that can degrade certain materials over time. If your fruiting chamber is constructed from plastic, it’s essential to verify the type of plastic used. Not all plastics are created equal; some, like high-density polyethylene (HDPE) or polypropylene (PP), are generally resistant to bleach and its fumes. However, plastics like polyvinyl chloride (PVC) or polystyrene may become brittle, discolored, or warped when exposed to bleach. Always check the manufacturer’s guidelines or conduct a small patch test to ensure compatibility before using bleach near plastic components.
For wooden fruiting chambers, the risks are equally important to address. Wood is naturally porous, which means it can absorb bleach fumes and moisture, leading to discoloration, weakening of the structure, or even mold growth if not properly sealed. If your chamber includes wooden elements, ensure they are treated with a bleach-resistant sealant or varnish. Alternatively, consider using naturally rot-resistant woods like cedar or redwood, which offer better durability in humid environments. Avoid using untreated or softwoods, as they are more susceptible to damage from bleach and moisture.
Another aspect to consider is the sealants and adhesives used in your fruiting chamber. If your setup relies on glues or sealants to hold materials together, verify their resistance to bleach. Silicone-based sealants, for example, are generally bleach-resistant and suitable for humid environments. Epoxy adhesives may also withstand bleach exposure, but it’s crucial to confirm compatibility with the specific product. Avoid using water-based or organic adhesives, as they can break down when exposed to bleach fumes.
In addition to the materials themselves, think about the long-term exposure of your fruiting chamber to bleach fumes. Even if your materials are initially resistant, prolonged or frequent exposure to bleach can accelerate wear and tear. To minimize risk, limit the use of bleach to necessary cleaning or sterilization tasks, and ensure proper ventilation during and after application. Consider using alternative disinfectants like hydrogen peroxide or vinegar, which are less likely to damage chamber materials while still providing effective sterilization.
Finally, monitoring and maintenance are key to preserving your fruiting chamber. Regularly inspect all components for signs of degradation, such as cracking, discoloration, or warping, especially after using bleach. Replace any damaged parts promptly to prevent further issues. By prioritizing material compatibility and taking proactive measures, you can ensure your fruiting chamber remains a safe and effective environment for growing mushrooms without being compromised by bleach fumes.
Why Mushrooms Are Suddenly Taking Over My Yard: Explained
You may want to see also

Alternative Sanitizers: Consider hydrogen peroxide or vinegar as safer mushroom-friendly disinfectants
When cultivating mushrooms, maintaining a clean and sterile environment is crucial for successful fruiting. However, the use of bleach, a common disinfectant, can pose risks due to its fumes, which may harm both the mycelium and the fruiting chamber. As an alternative, hydrogen peroxide and vinegar emerge as safer, mushroom-friendly sanitizers. These options are not only effective at eliminating contaminants but also less likely to leave harmful residues or fumes that could disrupt the delicate balance of your fruiting chamber.
Hydrogen peroxide (H₂O₂) is a powerful oxidizer that breaks down into water and oxygen, making it a safe and eco-friendly choice. A 3% solution of hydrogen peroxide can be used to sanitize surfaces, tools, and even the air in your fruiting chamber. To use, simply spray or wipe down surfaces, allow it to sit for 10–15 minutes, and then rinse or wipe away any residue. For air purification, a small amount can be placed in an open container inside the chamber to help reduce airborne contaminants without harming the mushrooms. Its non-toxic breakdown products ensure that it won't leave behind harmful fumes or chemicals that could inhibit mushroom growth.
Vinegar, specifically white distilled vinegar, is another excellent alternative due to its natural antimicrobial properties. Its acetic acid content effectively kills bacteria, mold, and other pathogens. A solution of 1 part vinegar to 1 part water can be used to clean surfaces and equipment. However, it’s important to rinse thoroughly after use, as the strong smell of vinegar can linger and potentially affect the fruiting environment. Vinegar is particularly useful for cleaning glass, plastic, and other non-porous surfaces in your fruiting chamber. Avoid using it on metal surfaces, as the acidity can cause corrosion over time.
Both hydrogen peroxide and vinegar offer distinct advantages over bleach. Unlike bleach, which releases chlorine fumes that can be toxic to mycelium and harmful to humans, these alternatives are gentle yet effective. They are also readily available, affordable, and easy to use, making them ideal for home mushroom growers. Additionally, their natural breakdown products ensure that they won’t leave behind residues that could interfere with mushroom development.
When implementing these alternatives, consistency is key. Regularly sanitize your fruiting chamber and tools to prevent contamination. For best results, combine these disinfectants with good hygiene practices, such as wearing clean gloves and using filtered air. By choosing hydrogen peroxide or vinegar, you can maintain a clean and safe environment for your mushrooms to thrive without the risks associated with bleach fumes. This approach not only protects your crop but also promotes a healthier and more sustainable growing process.
Death Cap Mushrooms in Ohio: Are They a Real Threat?
You may want to see also
Frequently asked questions
Bleach fumes can be harmful to your fruiting chamber if not used properly. Bleach is a strong disinfectant, but its fumes can kill beneficial mycelium and contaminate the environment. If you must use bleach, ensure the chamber is thoroughly aired out and rinsed with water before reintroducing mushrooms.
After using bleach, allow the fruiting chamber to air out for at least 24 hours in a well-ventilated area. Rinse all surfaces with clean water to remove any residual bleach before reintroducing mushroom cultures to ensure no harmful fumes remain.
Yes, safer alternatives include using a 70% isopropyl alcohol solution or hydrogen peroxide (3%). These are effective disinfectants with less risk of harming mycelium or leaving harmful residues. Always ensure proper ventilation and rinse surfaces with water if needed.


![Boomer Shroomer Inflatable Monotub Kit, Mushroom Growing Kit Includes a Drain Port, Plugs & Filters, Removeable Liner [Patent No: US 11,871,706 B2]](https://m.media-amazon.com/images/I/61K9zwzRQxL._AC_UL320_.jpg)

![Premium Mushroom Monotub [XLarge, 68Q Grow Kit] Portable and Compact Fruiting Chamber with Filter Discs, Liner and Adjustable Air Vents, 22.8 x 15.7” x 12”, Brown](https://m.media-amazon.com/images/I/71lbmVd8wdL._AC_UL320_.jpg)




















